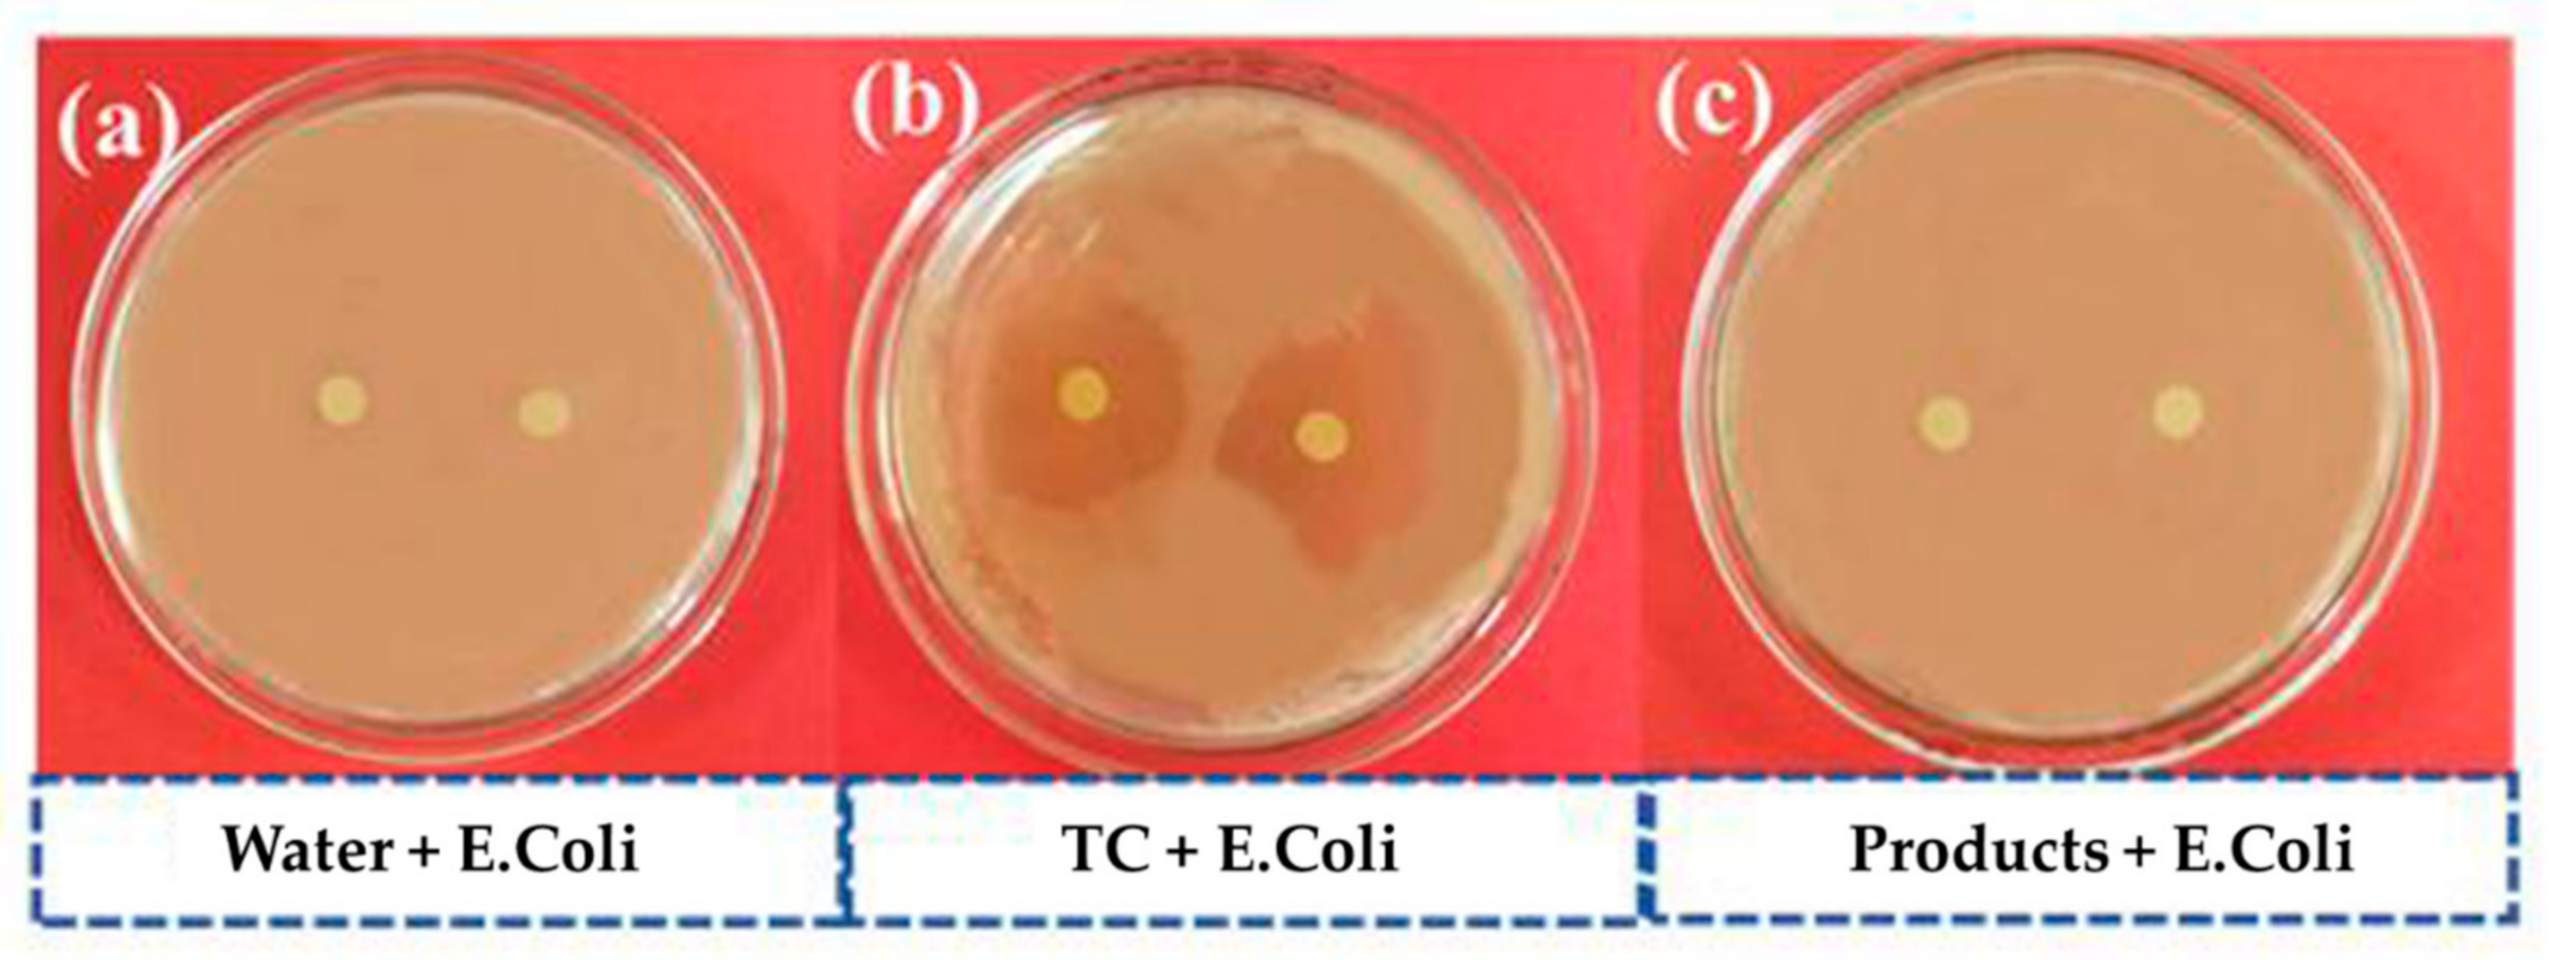
Catalysts 12 00221 g006

Facile Synthesis of Sillén-Aurivillius Layered Oxide Bi7Fe2Ti2O17Cl with Efficient Photocatalytic Performance for Degradation of Tetracycline
Abstract
:1. Introduction
2. Results and Discussion
2.1. Phase and Microstructure
2.2. Optical Property
2.3. Band Structures
2.4. Photocatalytic Activity
2.5. Degradation Pathway of TC and Toxicity Assessment of Products
2.6. Proposed Photocatalytic Mechanism
3. Materials and Methods
3.1. Materials
3.2. Preparation of BiOCl
3.3. Preparation of Bi7Fe2Ti2O17Cl
3.4. Preparation of Bi4NbO8Cl
3.5. Characterization
3.6. Theoretical Calculations
3.7. Photocatalytic Experiments
3.8. Electrochemical Measurement
3.9. Toxicity Assessment
4. Conclusions
Supplementary Materials
Author Contributions
Funding
Data Availability Statement
Conflicts of Interest
References
- Mansingh, S.; Sultana, S.; Acharya, R.; Ghosh, M.K.; Parida, K.M. Efficient Photon Conversion via Double Charge Dynamics CeO2-BiFeO3 p-n Heterojunction Photocatalyst Promising toward N2 Fixation and Phenol-Cr (VI) Detoxification. Inorg. Chem. 2020, 59, 3856–3873. [Google Scholar] [CrossRef] [PubMed]
- Prete, P.; Fiorentino, A.; Rizzo, L.; Proto, A.; Cucciniello, R. Review of Aminopolycarboxylic Acids-Based Metal Complexes Application to Water and Wastewater Treatment by (Photo-)Fenton Process at Neutral pH. Curr. Opin. Green. Sust. 2021, 28, 100451. [Google Scholar] [CrossRef]
- Zhou, J.; Ding, J.; Wan, H.; Guan, G. Boosting Photocatalytic Degradation of Antibiotic Wastewater by Synergy Effect of Heterojunction and Phosphorus Doping. J. Colloid. Interf. Sci. 2020, 582, 961–968. [Google Scholar] [CrossRef] [PubMed]
- Roberto, F.; Balsamo, S.A.; D’Urso, L.; Sciré, S.; Brundo, M.V.; Pecoraro, R.; Scalisi, E.M.; Privitera, V.; Impellizzeri, G. CeO2 for Water Remediation: Comparison of Various Advanced Oxidation Processes. Catalysts 2020, 10, 446. [Google Scholar]
- Moradi, M.; Vasseghian, Y.; Khataee, A.; Harati, M.; Arfaeinia, H. Ultrasound-Assisted Synthesis of FeTiO3/GO Nanocomposite for Photocatalytic Degradation of Phenol under Visible Light Irradiation. Sep. Purif. Technol. 2021, 261, 118274. [Google Scholar] [CrossRef]
- Huang, B.; Li, N.X.; Lin, W.L.; Li, H. A Highly Ordered Honeycomb-Like Nickel (III/II) Oxide-enhanced Photocatalytic Fuel Cell for Effective Degradation of Bisphenol A. J. Hazard. Mater. 2018, 360, 578–586. [Google Scholar] [CrossRef]
- Wang, D.; Jia, F.; Hou, W.; Fei, C.; Yuan, X. Simultaneously Efficient Adsorption and Photocatalytic Degradation of Tetracycline by Fe-Based MOFs. J. Colloid Interf. Sci. 2018, 519, 273–284. [Google Scholar] [CrossRef]
- Lanzafame, P.; Centi, G.; Perathoner, S. Catalysis for Biomass and CO2 Use through Solar Energy: Opening New Scenarios for A Sustainable and Low-Carbon Chemical Production. Chem. Soc. Rev. 2014, 43, 7562–7580. [Google Scholar] [CrossRef]
- Kubacka, A.; Fernández-García, M.; Colón, G. Advanced Nanoarchitectures for Solar Photocatalytic Applications. Chem. Rev. 2016, 112, 1555–1614. [Google Scholar] [CrossRef]
- Bhatkhande, D.S.; Pangarkar, V.G.; Beenackers, A.A.C.M. Photocatalytic Degradation for Environmental Applications-A Review. J. Chem. Technol. Biot. 2002, 77, 102–116. [Google Scholar] [CrossRef]
- Fujishima, A.; Honda, K. Electrochemical Photocatalysis of Water at Semiconductor Electrode. Nature 1972, 238, 37–38. [Google Scholar] [CrossRef] [PubMed]
- Dutta, V.; Sharma, S.; Raizada, P.; Thakur, V.K.; Singh, P. An Overview on WO3 Based Photocatalyst for Environmental Remediation. J. Environ. Chem. Eng. 2021, 14, 2519–2542. [Google Scholar] [CrossRef]
- Lu, X.W.; Li, X.Z.; Chen, F.; Chen, Z.G.; Zhang, Q.F. Biotemplating Synthesis of N-Doped Two-Dimensional CeO2-TiO2 Nanosheets with Enhanced Visible Light Photocatalytic Desulfurization Performance. J. Alloys Compd. 2019, 815, 152326. [Google Scholar] [CrossRef]
- Zhang, F.; Zhuang, H.Q.; Zhang, W.M.; Yin, J.; Cao, F.H.; Pan, Y.-X. Noble-Metal-Free CuS/CdS Photocatalyst for Efficient Visible-Light-Driven Photocatalytic H2 Production from Water. Catal. Today 2019, 330, 203–208. [Google Scholar] [CrossRef]
- Zhuang, J.; Tian, Q.; Lin, S.; Yang, W.; Chen, L.; Liu, P. Precursor Morphology-Controlled Formation of Perovskites CaTiO3 and Their Photo-Activity for As (III) Removal. Appl. Catal. B-Environ. 2014, 156, 108–115. [Google Scholar] [CrossRef]
- Han, N.; Xu, Q.X.; Beyene, G.; Zhang, Q.F. Enhanced Photocatalytic Activity over g-C3N4/(BiO)2(OH)xCl2-x Z-Scheme Heterojunction. Appl. Surf. Sci. 2020, 521, 146464. [Google Scholar] [CrossRef]
- Bahers, T.L.; Rérat, M.; Sautet, P. Semiconductors Used in Photovoltaic and Photocatalytic Devices: Assessing Fundamental Properties from DFT. J. Phys. Chem. C 2014, 118, 5997–6008. [Google Scholar] [CrossRef]
- Samsudin, M.F.R.; Ullah, H.; Bashiri, R.; Mohammed, N.M.; Yun, H.N. Experimental and DFT Insights on Microflower g-C3N4/BiVO4 Photocatalyst for Enhanced Photoelectrochemical Hydrogen Generation from Lake Water. ACS Sustain. Chem. Eng. 2020, 8, 9393–9403. [Google Scholar] [CrossRef]
- Zhang, L.S.; Wang, W.Z.; Yang, J.; Chen, Z.G.; Zhou, W.Q.L.; Liu, S.W. Sonochemical Synthesis of Nanocrystallite Bi2O3 as a Visible-Light-Driven Photocatalyst. Appl. Catal. A-Gen. 2006, 308, 105–110. [Google Scholar] [CrossRef]
- Zhang, X.; Ai, Z.; Jia, F.; Zhang, L. Generalized One-Pot Synthesis, Characterization, and Photocatalytic Activity of Hierarchical BiOX (X = Cl, Br, I) Nanoplate Microspheres. J. Phys. Chem. C 2008, 112, 747–753. [Google Scholar] [CrossRef]
- Zhang, L.; Wang, W.; Zhou, L.; Xu, H. Bi2WO6 Nano- and Microstructures: Shape Control and Associated Visible-Light-Driven Photocatalytic Activities. Small 2010, 3, 1618–1625. [Google Scholar] [CrossRef] [PubMed]
- Peng, Y.-H.; Zhang, Y.; Tian, F.H.; Zhang, J.Q.; Yu, J.Q. Structure Tuning of Bi2MoO6 and Their Enhanced Visible Light Photocatalytic Performances. Crit. Rev. Solid State Mater. Sci. 2017, 42, 1–26. [Google Scholar] [CrossRef]
- Xu, L.; Wan, Y.P.; Xie, H.D.; Huang, Y.L.; Qiao, X.B.; Qin, L.; Seo, H.J. On Structure, Optical Properties and Photodegradated Ability of Aurivillius-Type Bi3TiNbO9 Nanoparticles. J. Am. Ceram. Soc. 2016, 99, 3964–3972. [Google Scholar] [CrossRef]
- Fujito, H.; Kunioku, H.; Kato, D.; Suzuki, H.; Higashi, M.; Kageyama, H.; Abe, R. Layered Perovskite Oxychloride Bi4NbO8Cl: A Stable Visible Light Responsive Photocatalyst for Water Splitting. J. Am. Chem. Soc. 2016, 47, 2082–2085. [Google Scholar] [CrossRef] [PubMed]
- Zhen, S.; Zhu, L.; Dong, Z.; Fan, L.; Wang, B.; Zhang, Q.F. A New Bi-Based Oxychloride Bi4Ti0.5W0.5O8Cl as a Photocatalyst. Catal. Lett. 2018, 148, 2480–2486. [Google Scholar] [CrossRef]
- Meng, X.C.; Zhang, Z.S. Facile Synthesis of BiOBr/Bi2WO6 Heterojunction Semiconductors with High Visible-Light-Driven Photocatalytic Activity. J. Photochem. Photobiol. A 2015, 310, 33–44. [Google Scholar] [CrossRef]
- Ozaki, D.; Suzuki, H.; Ogawa, K.; Sakamoto, R.; Inaguma, Y.; Nakashima, K.; Tomita, O.; Kageyama, H.; Abe, R. Synthesis, Band Structure and Photocatalytic Properties of Sillén–Aurivillius Oxychlorides BaBi5Ti3O14Cl, Ba2Bi5Ti4O17Cl and Ba3Bi5Ti5O20Cl with Triple-, Quadruple- and Quintuple-perovskite Layers. J. Mater. Chem. A 2021, 9, 8332–8340. [Google Scholar] [CrossRef]
- Nakada, A.; Saeki, A.; Higashi, M.; Kageyama, H.; Abe, R. Two-step synthesis of Sillén-Aurivillius Type Oxychlorides to Enhance Their Photocatalytic Activity for Visible-Light-Induced Water splitting. J. Mater. Chem. A 2018, 6, 10909–10917. [Google Scholar] [CrossRef]
- Majumdar, A.; Ghosh, U.; Pal, A. Novel 2D/2D g-C3N4/Bi4NbO8Cl Nano-Composite for Enhanced Photocatalytic Degradation of Oxytetracycline under Visible LED Light Irradiation. J. Colloid Interface Sci. 2021, 584, 320–331. [Google Scholar] [CrossRef]
- Wei, Z.; Liu, J.; Shangguan, W. A Review on Photocatalysis in Antibiotic Wastewater: Pollutant Degradation and Hydrogen Production. Chin. J. Catal. 2020, 41, 1440–1450. [Google Scholar] [CrossRef]
- Xu, Y.; You, Y.; Huang, H.W.; Guo, Y.X.; Zhang, Y.H. Bi4NbO8Cl {001} Nanosheets Coupled with g-C3N4 as 2D/2D Heterojunction for Photocatalytic Degradation and CO2 Reduction. J. Hazard. Mater. 2020, 381, 121159. [Google Scholar] [CrossRef] [PubMed]
- Wu, X.L.; Zhang, Y.L.; Wang, K.; Zhang, S.; Qu, X.F.; Shi, L.; Du, F.-L. In-Situ Construction of Bi/Defective Bi4NbO8Cl for Non-noble Metal Based Mott-Schottky Photocatalysts towards Organic Pollutants Removal. J. Hazard. Mater. 2020, 393, 122408. [Google Scholar] [CrossRef] [PubMed]
- Chen, Z.; Hong, T.; Wang, Z.; Wang, J.; Huang, H.; Peng, R.; Yan, W.; Fu, Z.; Brinkman, K.S.; Lu, Y. Anisotropic Magnetic Property and Exchange Bias Effect in a Homogeneous Sillén-Aurivillius Layered Oxide. J. Eur. Ceram. Soc. 2019, 39, 2685–2691. [Google Scholar] [CrossRef]
- Zhu, X.D.; Wang, Y.J.; Sun, R.J.; Zhou, D.M. Photocatalytic Degradation of Tetracycline in Aqueous Solution by Nanosized TiO2. Chemosphere 2013, 92, 925–932. [Google Scholar] [CrossRef]
- Ding, J.; Dai, Z.; Qin, F.; Zhao, H.; Zhao, S.; Chen, R. Z-Scheme BiO1−xBr/Bi2O2CO3 Photocatalyst with Rich Oxygen Vacancy as Electron Mediator for Highly Efficient Degradation of Antibiotics. Appl. Catal. B Environ. 2017, 205, 281–289. [Google Scholar] [CrossRef]
- Lu, L.W.; Lv, M.L.; Wang, D.; Liu, G.; Xu, X.X. Efficient Photocatalytic Hydrogen Production over Solid Solutions Sr1−xBixTi1−xFexO3 (0 ≤ x ≤ 0.5). Appl. Catal. B Environ. 2017, 200, 412–419. [Google Scholar] [CrossRef]
- Jiang, L.; Ni, S.; Liu, G.; Xu, X.X. Photocatalytic Hydrogen Production over Aurivillius Compound Bi3TiNbO9 and Its Modifications by Cr/Nb Co-Doping. Appl. Catal. B Environ. 2017, 217, 342–352. [Google Scholar] [CrossRef]
- Hu, J.; Fan, W.; Ye, W.; Huang, C.; Qiu, X. Insights into the Photosensitivity Activity of BiOCl under Visible Light Irradiation. Appl. Catal. B Environ. 2014, 158–159, 182–189. [Google Scholar] [CrossRef]
- Ogawa, K.; Nakada, A.; Suzuki, H.; Tomita, O.; Higashi, M.; Saeki, A.; Kageyama, H.; Abe, R. Flux Synthesis of Layered Oxyhalide Bi4NbO8Cl Photocatalyst for Efficient Z-Scheme Water Splitting under Visible Light. ACS Appl. Mater. Inter. 2018, 11, 5642–5650. [Google Scholar] [CrossRef]
- Tauc, J. Optical Properties and Electronic Structure of Amorphous Germanium. Mater. Res. Bull. 1968, 3, 37–46. [Google Scholar] [CrossRef]
- Davis, A.P.; Hao, O.-J. Reactor Dynamics in the Evaluation of Photocatalytic Oxidation Kinetics. J. Catal. 1991, 131, 285–288. [Google Scholar] [CrossRef]
- Ning, D.; Zhang, L.; Hashimoto, M.; Iwasaki, K.; Meng, Q.-B. Enhanced Photocatalytic Activity of Mesoporous Carbon/C3N4 Composite Photocatalysts. J. Colloid Interface Sci. 2018, 512, 474–479. [Google Scholar]
- Yang, Y.; Zeng, Z.; Zhang, C.; Huang, D.; Zeng, G.; Xiao, R.; Lai, C.; Zhou, C.; Guo, H.; Xue, W. Construction of Iodine Vacancy-rich BiOI/Ag@AgI Z-Scheme Heterojunction Photocatalysts for Visible-Light-Driven Tetracycline Degradation: Transformation Pathways and Mechanism Insight. Chem. Eng. J. 2018, 349, 808–821. [Google Scholar] [CrossRef]
- Zhang, Y.; Zhou, J.B.; Chen, X.; Wang, L.; Cai, W.Q. Coupling of Heterogeneous Advanced Oxidation Processes and Photocatalysis in Efficient Degradation of Tetracycline Hydrochloride by Fe-Based MOFs: Synergistic effect and Degradation Pathway. Chem. Eng. J. 2019, 369, 745–757. [Google Scholar] [CrossRef]
- Bell, N.J.; Ng, Y.H.; Du, A.; Coster, H.; Smith, S.C.; Amal, R. Understanding the Enhancement in Photoelectrochemical Properties of Photocatalytically Prepared TiO2-Reduced Graphene Oxide Composite. J. Phys. Chem. C 2011, 115, 6004–6009. [Google Scholar] [CrossRef]
- Xie, L.; Yang, Z.; Xiong, W.; Zhou, Y.; Cao, J.; Peng, Y.; Li, X.; Zhou, C.; Xu, R.; Zhang, Y. Construction of MIL-53(Fe) Metal-organic Framework Modified by Silver Phosphate Nanoparticles as a Novel Z-scheme Photocatalyst: Visible-Light Photocatalytic Performance and Mechanism Investigation. Appl. Surf. Sci. 2019, 465, 103–115. [Google Scholar] [CrossRef]
- Shi, Q.; Zhang, Y.; Sun, D.; Zhang, S.; Cao, S. Bi2O3-Sensitized TiO2 Hollow Photocatalyst Drives the Efficient Removal of Tetracyclines under Visible Light. Inorg. Chem. 2020, 59, 18131–18140. [Google Scholar] [CrossRef]
- Majumdar, A.; Pal, A. Optimized Synthesis of Bi4NbO8Cl Perovskite Nanosheets for Enhanced Visible Light Assisted Photocatalytic Degradation of Tetracycline Antibiotics. J. Environ. Chem. Eng. 2020, 8, 103645. [Google Scholar] [CrossRef]
- Perdew, J.P.; Burke, K.; Ernzerhof, M. Generalized Gradient Approximation Made Simple. Phys. Rev. Lett. 1996, 77, 3865. [Google Scholar] [CrossRef] [Green Version]
- Heyd, J.; Scuseria, G.E.; Ernzerhof, M. Hybrid Functionals Based on a Screened Coulomb Potential. J. Chem. Phys. 2003, 118, 8207–8215. [Google Scholar] [CrossRef] [Green Version]
- Chen, C.; Zeng, H.; Yi, M.; Xiao, G.; Xu, S.; Shen, S.; Bo, F. In-Situ Growth of Ag3PO4 on Calcined Zn-Al Layered Double Hydroxides for Enhanced Photocatalytic Degradation of Tetracycline under Simulated Solar Light Irradiation and Toxicity Assessment. Appl. Catal. B Environ. 2019, 252, 47–54. [Google Scholar] [CrossRef]
- Afranio, C.F.; Rocha, M.K.; Jucá, M.E.J.; Oliveira, C.M.C.S.; Martins, M.A.A.; De, S.I.P.; Albuquerque, M.E.; Almeida, F.P.B. Silver Nanoparticles-Disk Diffusion Test Against Escherichia Coli Isolates. Rev. Inst. Med. Trop. Sao Paulo 2016, 58, 73. [Google Scholar]

Publisher’s Note: MDPI stays neutral with regard to jurisdictional claims in published maps and institutional affiliations. |
© 2022 by the authors. Licensee MDPI, Basel, Switzerland. This article is an open access article distributed under the terms and conditions of the Creative Commons Attribution (CC BY) license (https://creativecommons.org/licenses/by/4.0/).
Share and Cite
Gu, Y.; Yu, F.; Chen, J.; Zhang, Q. Facile Synthesis of Sillén-Aurivillius Layered Oxide Bi7Fe2Ti2O17Cl with Efficient Photocatalytic Performance for Degradation of Tetracycline. Catalysts 2022, 12, 221. https://doi.org/10.3390/catal12020221
Gu Y, Yu F, Chen J, Zhang Q. Facile Synthesis of Sillén-Aurivillius Layered Oxide Bi7Fe2Ti2O17Cl with Efficient Photocatalytic Performance for Degradation of Tetracycline. Catalysts. 2022; 12(2):221. https://doi.org/10.3390/catal12020221
Chicago/Turabian StyleGu, Yan, Fang Yu, Jikun Chen, and Qinfang Zhang. 2022. "Facile Synthesis of Sillén-Aurivillius Layered Oxide Bi7Fe2Ti2O17Cl with Efficient Photocatalytic Performance for Degradation of Tetracycline" Catalysts 12, no. 2: 221. https://doi.org/10.3390/catal12020221
APA StyleGu, Y., Yu, F., Chen, J., & Zhang, Q. (2022). Facile Synthesis of Sillén-Aurivillius Layered Oxide Bi7Fe2Ti2O17Cl with Efficient Photocatalytic Performance for Degradation of Tetracycline. Catalysts, 12(2), 221. https://doi.org/10.3390/catal12020221

